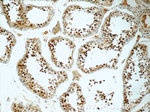
HIC1 Antibody in Immunohistochemistry (Paraffin) (IHC (P))

Search
Proteintech
HIC1 Polyclonal Antibody
{{$productOrderCtrl.translations['antibody.pdp.commerceCard.promotion.promotions']}}
{{$productOrderCtrl.translations['antibody.pdp.commerceCard.promotion.viewpromo']}}
{{$productOrderCtrl.translations['antibody.pdp.commerceCard.promotion.promocode']}}: {{promo.promoCode}} {{promo.promoTitle}} {{promo.promoDescription}}. {{$productOrderCtrl.translations['antibody.pdp.commerceCard.promotion.learnmore']}}
产品信息
24949-1-AP
种属反应
宿主/亚型
分类
类型
抗原
偶联物
形式
浓度
规格
纯化类型
保存液
内含物
保存条件
运输条件
产品详细信息
Immunogen sequence: DGAEAAAAA AVAPGAEPSL GAVLAAASYL QIPDLVALCK KRLKRHGKYC HLRGGGGGGG GYAPYGRPGR GLRAATPVIQ ACYPSPVGPP PPPAAEPPSG PEAAVNTHCA ELYASGPGPA AALCASERRC SPLCGLDLSK KSPPGSAAPE RPLAERELPP RPDSPPSAGP AAYKEPPLAL PSLPPLPFQK LEEAAPPSDP FRGGSGSPGP EPPGRPDGPS LLYRWMKHEP GLGSYGDELG RERGSPSERC EERGGDAAVS PGGPPLGLAP PPRYPGSLDG PGAGGDGDDY KSSSEETGSS EDPSPPGGHL EGYPCPHLAY G (89-408 aa encoded by BC157027)
靶标信息
Hypermethylated in cancer (HIC-1) was originally identified as a target of p53-induced gene expression. HIC-1 is deleted in the genetic disorder Miller-Dieker syndrome (MDS), and the expression of HIC-1 is also frequently suppressed in leukemia and various cancers due to the hypermethylation of specific DNA regions and the resulting transcriptional silencing. These and other studies indicate that HIC-1 acts as a putative tumor suppressor protein that mediates transcriptional repression. HIC-1 is ubiquitously expressed in adult tissues and its structure is defined by five zinc fingers and an N-terminal broad complex POZ (or BTB) domain. In several BTB/POZ containing proteins, including BCL-6 and the promyelocytic leukemia zinc-finger (PLZF) oncoprotein, this domain interacts with the SMRT/N-CoR-mSin3A HDAC complex and is directly involved in repressing and silencing gene transcription. When this domain is deleted, as with the oncogenic PLZF-RAR chimera of promyelocytic leukemias, this transcriptional repression is attenuated. Conversely, HIC-1 does not interact with components of the HDAC complex, suggesting that HIC-1-induced transcriptional repression is unassociated with the POZ/BTB domain.
仅用于科研。不用于诊断过程。未经明确授权不得转售。
生物信息学
蛋白别名: Hic-1; hypermethylated in cancer 1; Hypermethylated in cancer 1 protein; hypermethylated in cancer-1; Zinc finger and BTB domain-containing protein 29
基因别名: AA408311; HIC-1; HIC1; ZBTB29; ZNF901
UniProt ID: (Human) Q14526, (Mouse) Q9R1Y5
Entrez Gene ID: (Human) 3090, (Mouse) 15248